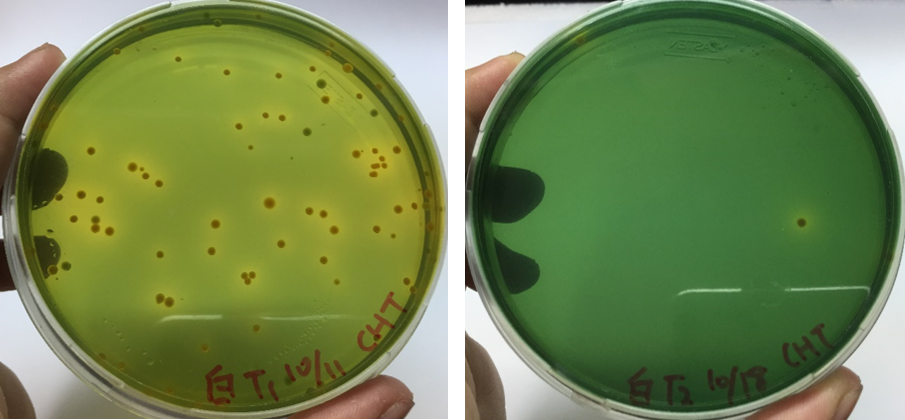
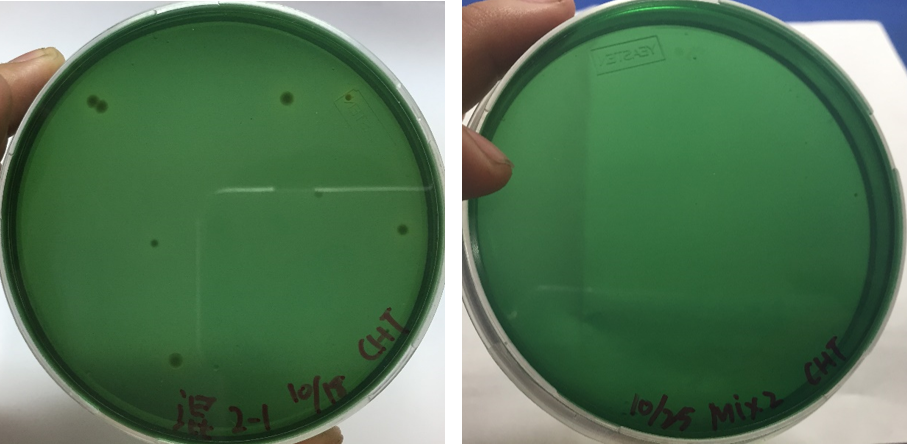

能拮抗多種病原菌之Bacillus pumilus D5田間試驗成果
益生菌在水產養殖上的應用,近年來可說是方興未艾,其主要目的有改善養殖環境、增加營養及提高飼料利用率、降低養殖生物疾病發生率、減少抗生素的濫用、提高抗病能力及免疫力,增加養殖收益。
而在這麼多五花八門的益生菌選項之中,能用以健康管理,達到以菌制菌,直接降低環境病源量,最常被用來作為生物控制的益生菌主要有枯草桿菌(Bacillus subtilis)、液化澱粉芽孢桿菌(B. amyloliquefaciens)、以及短小芽孢桿菌(B. pumilus)(Nair et al., 2012),不過同樣是短小芽孢桿菌,可能會因品種不同而在功能上有極大差異。
其中水產試驗所研發之短小芽孢桿菌B. pumilus D5已被證實具有多樣抗病原能力,不僅能拮抗蝦類主要的細菌性疾病病原,包括溶藻弧菌(Vibrio alginolyticus)、腸炎弧菌(V. parahaemolyticus)、哈維氏弧菌(V. harveyi)等,魚類病原的哈維氏弧菌、鰻弧菌(V. anguillarum)、創傷弧菌(V. vulnificus),甲魚病原的仙人掌桿菌(Bacillus cereus),瓶鼻海豚鏈球菌(Streptococcus iniae)、S. agalactiae (無乳鏈球菌)等...(Huang et al., 2016),根據文獻(Aly et al., 2008)及本公司的對峙培養實測,D5也能拮抗淡水觀賞魚最常見的親水性產氣單孢菌(Aeromonas hydrophila)(表1)。

在水試所先前的實驗中,已知於飼料中添加B. pumilus D5餵食白蝦8週後,能有效降低白蝦養殖環境與肝胰腺之弧菌數,並提升白蝦之免疫反應及抗弧菌感染之功能,且以腸炎弧菌進行攻擊後,整體存活率高於對照組3.4倍(Huang et al., 2016),而根據文獻報導,直接在養殖池水中添加B. pumilus 不僅能使水中弧菌量在18天內降低100倍,並且能提高草蝦存活率及成長率(Banerjee et al., 2010),甚至直接在牡蠣養殖池內使用B. pumilus,也能提高牡蠣的免疫力,進而幫助牡蠣抵抗弧菌感染,並提升病菌攻擊後的存活率(Karim et al., 2013)。
然而,B. pumilus D5在實際的田間使用上,是否能與文獻一樣達到抑制弧菌的效果,則是此次實驗所欲探討的重點,此次試驗商借兩場位於高雄永安的白蝦室內養殖苗場(圖1)及白蝦及虱目魚室外混養池(圖2),將含有B. pumilus D5菌粉的產品直接添加在池水中,使水中達到有效菌量,並在產品使用前及一週後,各取定量池水進行測試,於實驗室的無菌操作台內各取100 µl水樣,均勻塗佈在TCBS培養基上,於30℃避光恆溫培養箱培養16小時,觀察培養基上菌落生長狀況及顏色判斷,用以比較使用益生菌產品前後,養殖池水中弧菌量是否有所改變。
TCBS培養基也稱為弧菌選擇性培養基,是一種常用來檢驗弧菌的培養基,若弧菌生長於其上,會依代謝方式不同而呈現不同顏色,無法利用蔗糖的細菌,例如腸炎弧菌等,在培養基上會呈現綠色;而能夠利用蔗糖的細菌則呈現黃色,例如溶藻弧菌及哈維氏弧菌等,雖然並不是生長其上的都是弧菌,不過仍不失為一種用來快速判斷弧菌數量的方法。
從實驗結果發現,在使用含有B. pumilus D5的產品一週後,不論室內苗場(圖3)或室外混養池(圖4),水中弧菌量皆有明顯下降(圖片左方培養基為使用前,右方為使用後),原本室內苗場池水中,弧菌量已達可能致病的濃度,卻在一週後降低至安全濃度,抑制效果高達99%,而在室外混養池中,弧菌量也有明顯降低 (表2),此項結果也顯示,B. pumilus D5用以生物控制上相當有效,效果甚至比其他文獻所述還要優秀。
不過在實驗過程中也觀察到,做好環境控制及持續使用益生菌的池子中,弧菌量原本就較少,而在養殖生物密度過高,營養鹽含量破表的案例中,B. pumilus D5也難以發揮抑菌功效,因此要達到控制病原菌的效果,首先應從改善養殖環境做起,若飼養密度高加上水質控制不佳,使用目前菌量是無法抑制的,需要提高用量或直接將產品作為飼料添加使用(單位菌量較高),才會有較明顯效果。
水生生物之所以會被病原菌感染,都與感染三要素有關,分別是宿主狀態、病原濃度、以及生活環境,因此要降低感病風險,就要從此三項要素著手,設法提高宿主免疫力,降低病原密度,或改善養殖環境,不過這三項要素往往是互相連動的,例如環境不佳造成免疫力下降及病原菌孳生,生物體因此被病菌趁虛而入,因此在健康管理上,也必須就綜合層面來考慮,此次使用的B. pumilus D5產品,不僅能達到提高宿主免疫力及降低病原密度之功效,對於改善環境水質也多有助益,在這幾則測試中,氨、亞硝酸、硝酸濃度皆有明顯降低,因此要達到抗弧菌的效果,不光從病原著手,環境控制也相當重要。
益生菌雖然有許多優點,但他並非萬能,使用益生菌要有預防勝於治療的概念,亦無法取代打氣換水、清潔殺菌及生病用藥的流程,但能作為環境控制及健康管理上的輔助,不論是環境控型或是增加產量型益生菌,產品種類皆相當多樣,除了要慎選產品之外,也要了解用法,才能收到應有的效果。



圖1. 高雄永安的白蝦室內養殖苗場

圖2. 高雄永安的白蝦及虱目魚於室外混養池
圖3. 白蝦室內苗場使用B. pumilus D5產品前後,水中弧菌量的變化
圖4. 白蝦室外混養池使用B. pumilus D5產品前後,水中弧菌量的變化




